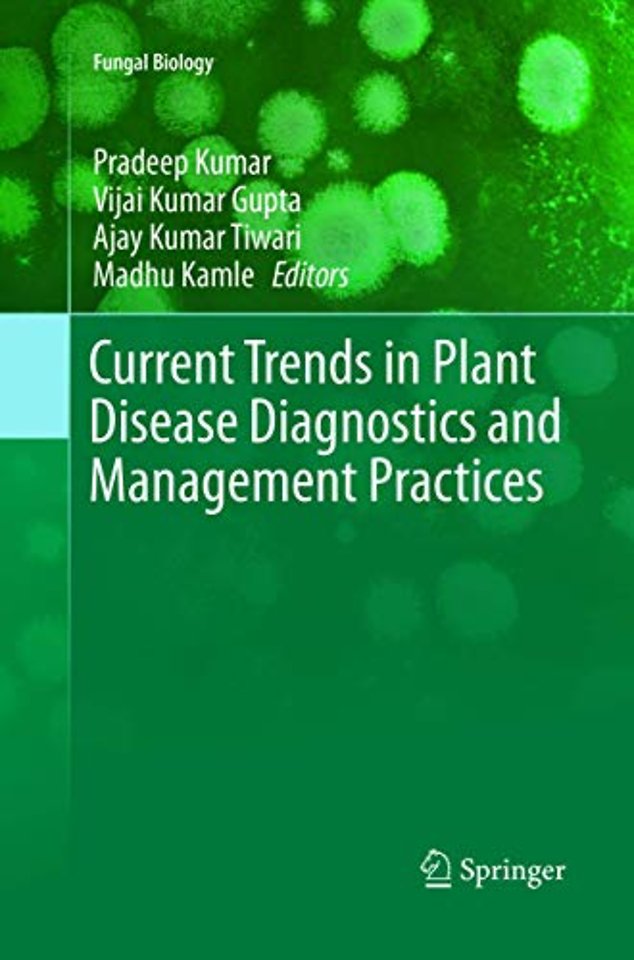
Current Trends in Plant Disease Diagnostics and Management Practices

Current Trends in Plant Disease Diagnostics and Management Practices
Samenvatting
Plant diseases play an important role on our daily lives. Most of plant diseases are visible and are caused by biotic and/or abiotic factors. Symptoms are usually the results of a morphological change, alteration or damage to plant tissue and/or cells due to an interference of the plant’s metabolism. All basic structures of vascular plants are subject to attack by pathogens. The failure in accurate disease diagnosis and management may lead to huge losses in plant production and related commodities, which causes nutritional food scarcity. Typically, the appearance of a biotic symptom will indicate the relatively late stage of an infection and/or colonization of a pathogen. Expert detection, accurate diagnosis, and timely management play a significant role in keeping plants free from pathogens. In this book expert scholars share their research knowledge and key literature which are vital toward the diagnosis of plant diseases across the globe, addressing traditional plant pathology techniques, as well as advanced molecular diagnostic approach.
Specificaties
Inhoudsopgave
Biocontrol Mechanism of Bacillus for Fusarium Wilt Management in Cumin (Cuminum Cyminum L.).- Eco Friendly Management
of Damping-off of Solanaceous Crops Caused by Pythium Species.- Biological
Agents in Fusarium Wilt (FW) Diagnostic for Sustainable Pigeon Pea Production,
Opportunities and Challenges.- Recent
Diagnostics and Detection Tools: Implications for Plant Pathogenic Alternaria and Their Disease Management.- Molecular
Prospecting: Advancement in Diagnosis and Control of Rhizoctonia Solani Diseases in Plants.- Fusarium moniliforme Associated with Sugarcane Leaf Binding Disease
in India and Its Possible Management.- Macrophomina
phaseolina: The Most Destructive Soybean Fungal Pathogen of Global Concern.- Colletotrichum gloeosporioides: Pathogen of Anthracnose
disease in Mango (Mangifera indica L.)
era Indica L.)</p><p></p><div><br>
</div><p></p><p></p>